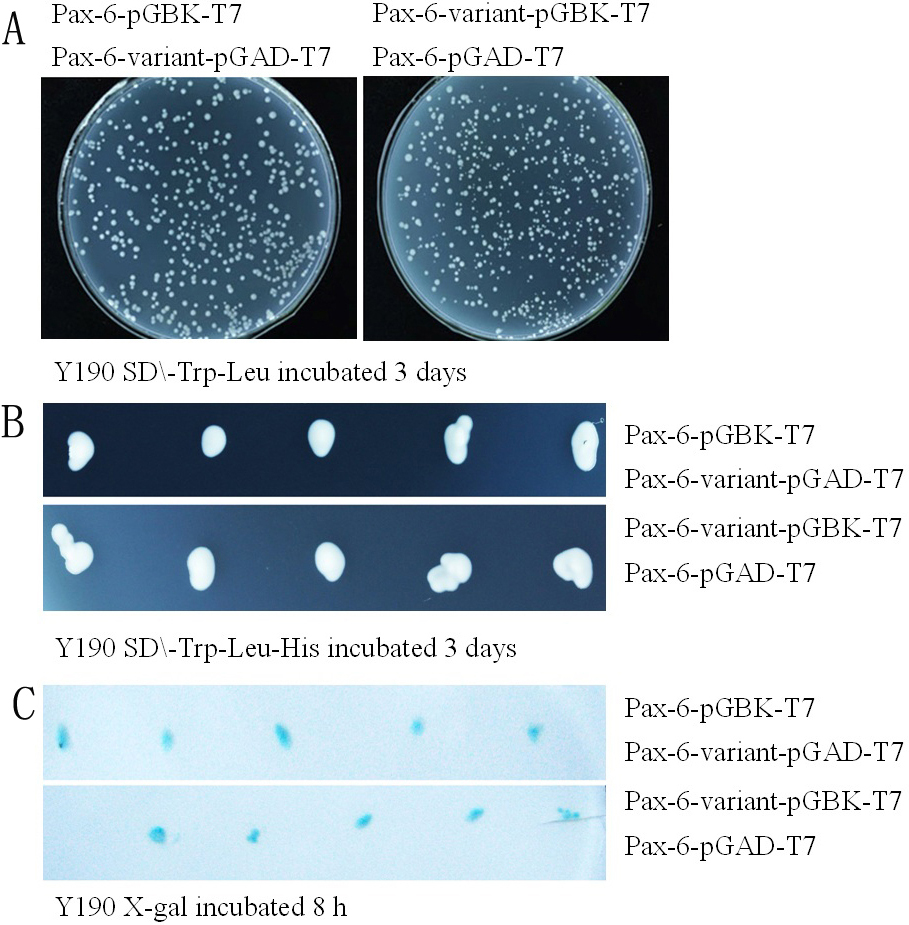

Figure 3. Yeast 2-hybrid system. A: Yeast Y190 grow in culture medium without Leu and Trp for 3 days at 30 degrees centigrade; Pax6-pGBK-T7 and Pax6-variant-pGAD-T7
were transformed into the first yeast colony, Pax6-pGAD-T7 and Pax6-variant-pGBK-T7 were transformed into the second yeast
colony. B: Yeast colony of the experimental group grew in culture medium containing dicyandiamide, without Leu, Trp, and His, after
growing for 3 days at 30 °C. C: yeast colony transformed into nitrocellulose filter membrane; adding buffer containing x-gal, the color is displayed blue.